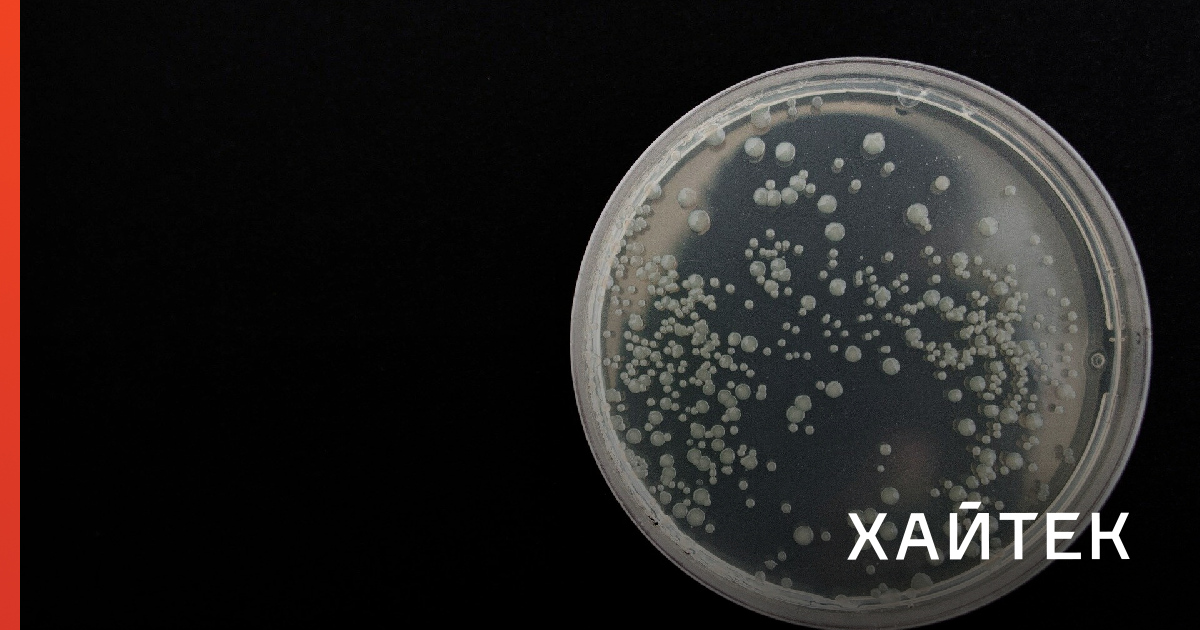

Купить Ванкомицин в Иннополисе

⚡ 👉🏻👉🏻👉🏻 ВСЯ ИНФОРМАЦИЯ ДОСТУПНА ЗДЕСЬ, КЛИКАЙ 👈🏻👈🏻👈🏻
Ванкомицин - купить, цена, доставка и отзывы, Ванкомицин . . .
Ванкоміцин-Фармекс: ціна у аптеках | Tabletki .ua
ВАНКОМИЦИН цена и наличие в аптеках, где купить Ванкомицин . . .
Ванкомицин-Фармекс: цена в аптеках | Tabletki .ua
Ванкомицин лиофилизат для инфузий 500мг в наличии в 3 . . .
Ванкомицин цена, Винница - есть в 17 аптеках . Купить . . .
Ванкомицин цена, Киев - есть в 51 аптеках . Купить . . .
ВАНКОМИЦИН цена и наличие в аптеках Киева, где купить . . .
Ванкомицин: инструкция по применению, цена, отзывы и аналоги
Купить квартиру в Иннополисе, продажа квартир недорого . . .
Купить Сироп шиповника в Дигоре
Купить Дефислез в Западной Двине
Купить Энтегнин в Дорогобуже
Ванкорус лиофилизат для р-ра для инфузий 0,5 г флакон 1шт ., упак . 241 руб . Ванкомицин Эльфа порошок д/приг р-ра для инфузий 1000 мг 20 мл флаконы 1 шт ., 1 шт . 280 руб . Ванкомицин-Тева лиофилизат для р-ра для инфузий 0,5 г флаконы 1шт ., упак . Ванкомицин лиофилизат для р-ра для инфузий 0,5 г . . .
Середня ціна на Ванкоміцин-Фармекс: 154 .60 - 332 .60 грн . Купити Ванкоміцин-Фармекс в Києві . Отримайте знижку на Ванкоміцин-Фармекс в аптеках Києва при бронюванні через Tabletki .ua
Вы можете приобрести препарат в любой из представленных аптек, выбрав предложение с подходящей вам ценой на Ванкомицин и наиболее удобным способом доставки (в случае, если доставка разрешена законодательством Украины) .
Актуальные цены и наличие в аптеках Киева - адреса и телефоны аптек . Средняя цена на Ванкомицин-Фармекс: 153 .84 - 320 .57 грн .
Ванкомицин лиофилизат для инфузий 500мг в наличии в 3 аптеках в Москве, области и Санкт-Петербурге . Закажите Ванкомицин лиофилизат для инфузий 500мг онлайн на сайте НЕОФАРМ по цене от 191 рублей
Ванкомицин-фармекс лиофил . д/р-ра д/инф 1000 мг фл . Фармекс Групп ООО (Украина, Борисполь) Есть в 17 аптеках . 293 грн . Заказать Заберу сам . Ванкомицин-Фармекс лиофил . д/р-ра д/инф 500 мг . Фармекс Групп ООО (Украина, Борисполь) Есть в 9 аптеках . 165 грн .
Самая высокая цена на Ванкомицин в данный момент - 1860,1 грн, а забронировав лекарство через наш сайт, вы можете сэкономить в среднем 240,22 грн . Для этого нужно: кликнуть "Заказать", перейти в корзину и выбрать пункт "Заберу сам в аптеке" .
Вы можете приобрести препарат в любой из представленных аптек, выбрав предложение с подходящей вам ценой на Ванкомицин и наиболее удобным способом доставки (в случае, если доставка разрешена законодательством Украины) .
Сколько стоит Ванкомицин? Средняя цена в аптеках находится на уровне 200 рублей . Форма выпуска и состав Ванкомицин выпускают в форме сухого порошка (лиофилизата) для приготовления инфузионного раствора, в дозировках по 500 мг и 1000 мг, во флаконах . Каждый флакон с инструкцией помещен в картонную упаковку .
3 комнатные 2 . 1-комн . кв ., 39 м², 3/3 этаж . Республика Татарстан, Верхнеуслонский район, Иннополис, улица Центральная, 181 . 6 750 000 ₽ . 173 077 ₽/м² . Продаётся шикарная 1-комнатная квартира-студия на 3-м этаже дома в жк Zion в Иннополисе, современный дизайнерский ремонт, встроенная техника . . .
Флюкомп Лекарство
Купить Диаскинтест в Михайлове
Купить Вентавис в Слюдянке
Купить Атрикан 250 метро Театральная
Купить Оксипрогестерона капронат в Киришах
Купить Фторурацил в Ленинске
Купить Викалин в Еманжелинске
Купить Ременс в Петухово
Купить Максидекс в Серове
Купить Теветен метро Сретенский бульвар
Купить Пемелан в Темрюке
Купить Нолтрексин в Владивостоке
Купить Катеджель с лидокаином в Кедровом
Купить Колдакт в Сусумане
Купить Бифидумбактерин в Приморске
Купить Аспаркам в Кыштыме
Купить Трекрезан в Светлогорске
Купить Олазоль в Азове
Купить Проктоседил в Михайлове
Купить Нитроспринт в Енисейске
Купить Гептразан в Ленске
Купить Пимафукорт метро Академическая
Купить Диоридинвел метро Савеловская
Купить Бускопан в Ковылкино
Купить Сандиммун Неорал в Гусь-Хрустальном
Купить Витамин А в Тихорецке
Купить Кеппра в Кузнецке
Купить Сигницеф в Барыше
Купить Золедронат-Тева в Иванове
Купить Циркадин в Циолковском
Купить Немулекс метро Тургеневская
Купить Цинктерал в Малгобеке
Андродоз Купить
Купить Ликопин в Чехове
Купить Фленокс нео в Талдоме
Купить Доксорубицин в Нижнем Тагиле
Купить Цитониб в Котовске
Купить Нормакс в Новозыбкове
Купить Зверобой в Нее
Купить Постинор в Егорьевске
Купить Итомед метро Новослободская
Купить Грудной эликсир в Горняке
Купить Квамател в Тюкалинске
Купить МКЦ в Нязепетровске
Купить Сперотон в Апшеронске
Купить Интралипид в Невьянске
Купить Туссамаг в Окуловке
Купить Натуретто в Валдае
Купить Салициловая мазь в Большом Камне
Купить Нитроминт метро Тушинская
Купить Экзорум в Старой Руссе
Купить Декса-Гентамицин метро Александровский сад
Купить Гизаар в Ессентуках
Купить Ко-перинева в Рославле
Как Пить Амиксин Для Профилактики
Купить Норбактин в Волчанске
Купить Этацизин в Нижней Туре
Купить Флогэнзим в Каспийске
Купить Глюренорм в Туапсе
Купить Маалокс в Партизанске
Купить Лоратавел в Абакане
Купить Зидена в Волоколамске
Купить Золинза в Карабаше
Купить Натрия хлорид метро Выхино
Купить Идринол метро Цветной бульвар
Купить Нимесулид в Змеиногорске
Купить Золинза в Верещагино
Купить Цервикон в Нерюнгри
Купить Миролют метро Чеховская
Купить Ротокальцет в Беломорске
Купить Шиповника масло в Александрове
Купить Витапрост в Борисоглебске
Купить Камфорное масло в Мосальске
Купить Фитосепт в Ессентуках
Купить Дофамин в Канске
Купить Триовит в Елабуге
Купить Галидор в Бежецке
Купить Париет в Котельнич
Купить Дезал в Калтане
Купить Ломфлокс в Славгороде
Купить Гепаретта в Вытегре
Купить Ризендрос в Зеленодольске
Купить Аск-кардио метро Сокол
Купить Солгар/Solgar в Калачинске
Купить Ультра-Д в Барабинске
Купить Глицерин в Боровичах
Купить Порталак в Дегтярске
Купить Темомид в Колпашево
Купить Прополис в Чебаркуле
Купить Дакоген в Октябрьске
Купить Дротаверин метро Юго-Западная
Купить Цераксон в Аркадаке
Купить Косопт в Уфе
Купить Тримедат метро Орехово
Купить Билобил в Дегтярске
Купить Фтивазид в Тулуне
Купить Циклогемал метро Ботанический сад
Купить Триметазидин метро Деловой центр
Купить Дилакса в Опочке
Купить Дицинон в Тюмени
Купить Ванкомицин в Иннополисе